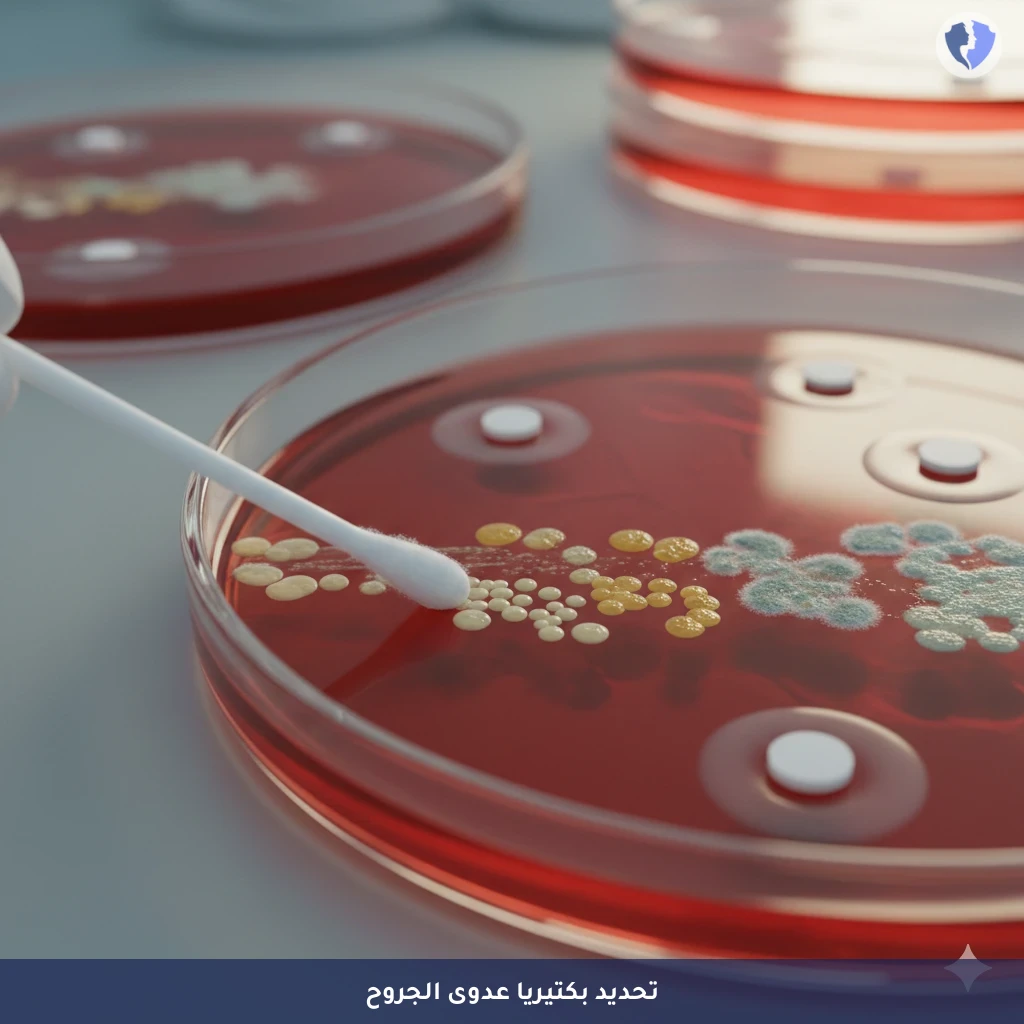
فحص مزرعة الجروح والالتهابات - مزرعة وحساسية مسحة من الجرح (Swab Culture and Sensitivity)

تفاصيل الخدمة
فحص مزرعة الجروح والالتهابات - مزرعة وحساسية مسحة من الجرح (Swab Culture and Sensitivity)
فحص مخبري يشمل زراعة عينة مسحة من مواقع مختلفة من الجسم لتحديد البكتيريا أو الفطريات المسببة للعدوى، واختبار حساسيتها للمضادات الحيوية.